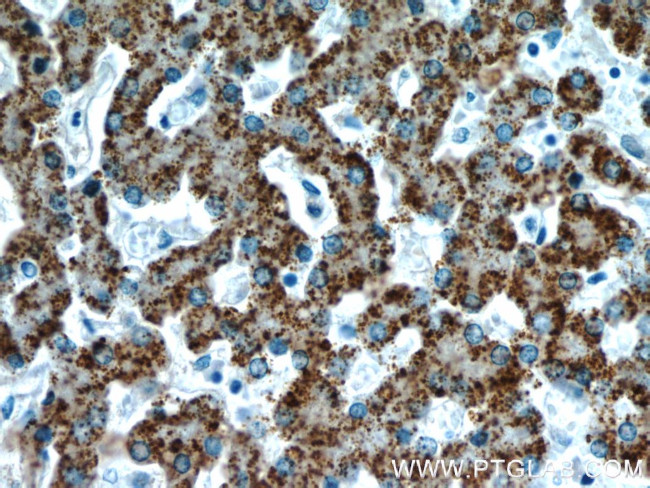
AGXT Antibody in Immunohistochemistry (Paraffin) (IHC (P))
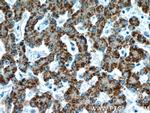
AGXT Antibody in Immunohistochemistry (Paraffin) (IHC (P))

Search
Proteintech
AGXT Polyclonal Antibody
{{$productOrderCtrl.translations['antibody.pdp.commerceCard.promotion.promotions']}}
{{$productOrderCtrl.translations['antibody.pdp.commerceCard.promotion.viewpromo']}}
{{$productOrderCtrl.translations['antibody.pdp.commerceCard.promotion.promocode']}}: {{promo.promoCode}} {{promo.promoTitle}} {{promo.promoDescription}}. {{$productOrderCtrl.translations['antibody.pdp.commerceCard.promotion.learnmore']}}
产品信息
22394-1-AP
种属反应
宿主/亚型
分类
类型
抗原
偶联物
形式
浓度
规格
纯化类型
保存液
内含物
保存条件
运输条件
产品详细信息
Immunogen sequence: MASHKLLVT PPKALLKPLS IPNQLLLGPG PSNLPPRIMA AGGLQMIGSM SKDMYQIMDE IKEGIQYVFQ TRNPLTLVIS GSGHCALEAA LVNVLEPGDS FLVGANGIWG QRAVDIGERI GARVHPMTKD PGGHYTLQEV EEGLAQHKPV LLFLTHGESS TGVLQPLDGF GELCHRYKCL LLVDSVASLG GTPLYMDRQG IDILYSGSQK ALNAPPGTSL ISFSDKAKKK MYSRKTKPFS FYLDIKWLAN FWGCDDQPRM YHHTIPVISL YSLRESLALI AEQGLENSWR QHREAAAYLH GRLQALGLQL FVKDPALRLP TVTTVAVPAG YDWRDIVSYV IDHFDIEIMG GLGPSTGKVL RIGLLGCNAT RENVDRVTEA LRAALQHCPK KKL (1-392 aa encoded by BC132819)
靶标信息
This gene is expressed only in the liver and the encoded protein is localized mostly in the peroxisomes, where it is involved in glyoxylate detoxification. Mutations in this gene, some of which alter subcellular targetting, have been associated with type I primary hyperoxaluria.
仅用于科研。不用于诊断过程。未经明确授权不得转售。
生物信息学
蛋白别名: AGT; AGTC; AGXT homolog; Alanine--glyoxylate aminotransferase; alanine--glyoxylate and serine--pyruvate aminotransferase; alanine-glyoxylate aminotransferase 1; hepatic peroxisomal alanine:glyoxylate aminotransferase; L-alanine: glyoxylate aminotransferase 1; Serine--pyruvate aminotransferase; Serine--pyruvate aminotransferase, mitochondrial; serine--pyruvate aminotransferase, peroxisomal; serine-pyruvate aminotransferase; SPT; unnamed protein product
基因别名: AGT; AGT1; AGXT; AGXT1; PH1; Ser-PyrAT; SPAT; SPT; TLH6
UniProt ID: (Human) P21549, (Mouse) O35423
Entrez Gene ID: (Human) 189, (Mouse) 11611